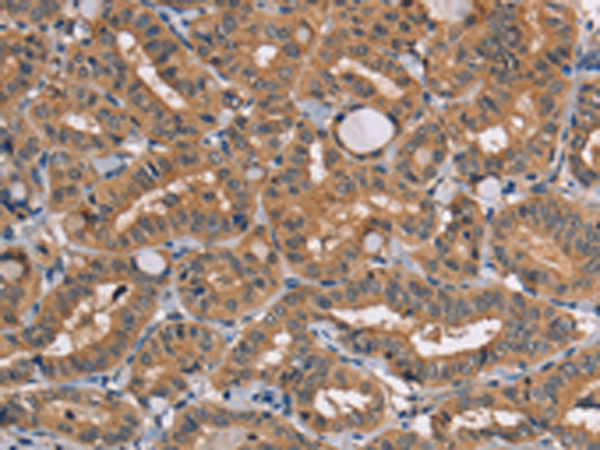

|
Background: |
The innate immune system confers host defense against viral and microbial infection, and TRAFD1 is a negative feedback regulator that controls excessive immune responses. Negative feedback regulator that controls excessive innate immune responses. Regulates both Toll-like receptor 4 (TLR4) and DDX58/RIG1-like helicases (RLH) pathways. May inhibit the LTR pathway by direct interaction with TRAF6 and attenuation of NF-kappa-B activation. |
|
Applications: |
ELISA, WB, IHC |
|
Name of antibody: |
TRAFD1 |
|
Immunogen: |
Fusion protein of human TRAFD1 |
|
Full name: |
TRAF-type zinc finger domain containing 1 |
|
Synonyms: |
FLN29 |
|
SwissProt: |
O14545 |
|
ELISA Recommended dilution: |
1000-2000 |
|
IHC positive control: |
Human thyroid cancer and human brain |
|
IHC Recommend dilution: |
25-100 |
|
WB Predicted band size: |
65 kDa |
|
WB Positive control: |
Mouse spleen tissue |
|
WB Recommended dilution: |
200-1000 |
購物車
幫助
021-54845833/15800441009
